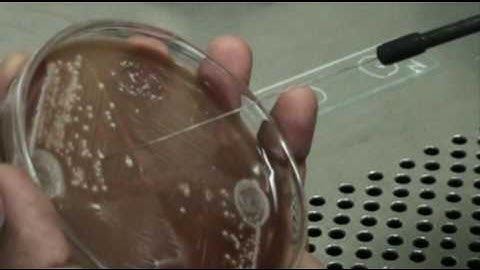
Coagulase test

⬇ DOWNLOAD NOW
Kalau muncul iklan pop-up, tutup lalu klik tombol kembali
Download lagu How to identify Staphylococcus aureus using the Coagulase Test - Slide and Tube Method secara gratis hanya untuk keperluan promosi. Dukung artis favorit kamu dengan membeli musik original di iTunes atau platform resmi lainnya.
 Coagulase Test
Coagulase Test
 How to Perform the Catalase Test - Staphylococcus vs Streptococcus
How to Perform the Catalase Test - Staphylococcus vs Streptococcus
 Coagulase Test for Staphylococcus
Coagulase Test for Staphylococcus
 Coagulase Test | Staphylococcus aureus detection | Pathogen Detection | Basic Science Series
Coagulase Test | Staphylococcus aureus detection | Pathogen Detection | Basic Science Series
 Slide and tube coagulase tests_
Slide and tube coagulase tests_
 Coagulase test for Staphylococcus aureus
Coagulase test for Staphylococcus aureus
Coagulase test
Coagulase test
 Tube coagulase Test | Clear Explain
Tube coagulase Test | Clear Explain